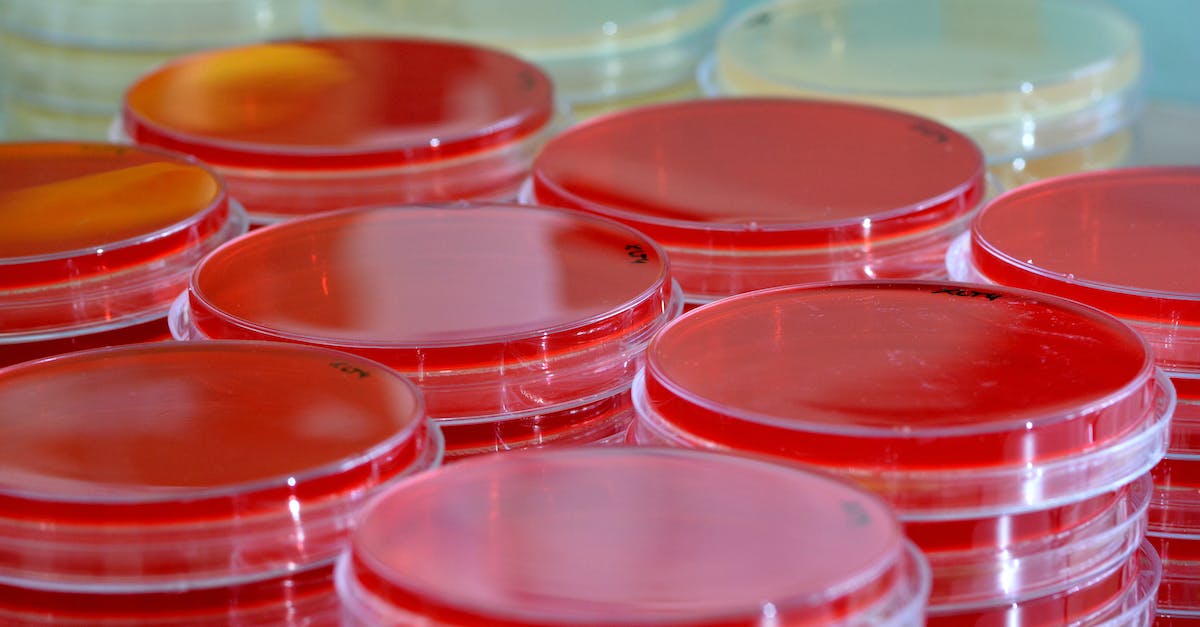
How do I get a blood sample from the Manbat? - Transparent containers with blood samples in lab

How do I get a blood sample from the Manbat?
//ads -- adsterra.com -- native banner
?>
I have the sidequest to get a blood sample from the Manbat to learn about it. I have found the creature flying around the city but I can't figure out how to draw blood from it. I have tried throwing Batarangs, remote batarangs, firing the claw at it and gliding next to it. None of those yielded results and the game doesn't give any hints on how to advance the quest.
Pictures about "How do I get a blood sample from the Manbat?"

Where is Man-Bat last location?
Founders' Island \u2013 Man-Bat's final location is around a large chunk of Ryker Heights in the northwest corner of Founders' island.Who is Man-Bat in Arkham Knight?
A gifted scientist who was diagnosed with a rare condition that caused chronic deafness, Dr. Kirk Langstrom went to extreme lengths to develop a cure. Splicing his DNA with that of a vampire bat transformed Kirk into a hideous monstrosity known as Man-Bat.Taking Man-Bat's Blood Sample - Batman: ARKHAM KNIGHT
Sources: Stack Exchange - This article follows the attribution requirements of Stack Exchange and is licensed under CC BY-SA 3.0.
Images: Karolina Grabowska, Karolina Grabowska, Alena Shekhovtcova, Jorge SepĂșlveda
